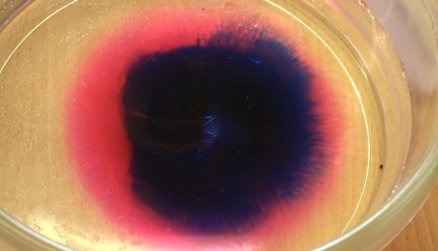

Els alumnes i la Margarita Andreu assagen possibles estructures per espais afegits. Amb tires de papers de diferents tipus i organitzats per petits grups, construeixen les maquetes dels esquelets dels espais imaginats.
Mar Arza EN RESiDÈNCiA a l’Institut Narcís Monturiol: construint frases a partir de paraules retallades
De les pàgines de La pluja als vidres, de Mª Aurèlia Capmany, en retallen aquelles paraules que els resulten més suggerents, evocadores o interessants. Després, amb el conjunt de paraules o expressions retallades, construeixen frases.
En un segon moment, distribueixen aquestes fases sobre imatges o objectes de l’aula creant així nous sentits o ressonàncies per les paraules.
Margarita Andreu EN RESiDÈNCiA a l’Institut Vall d’Hebron: assaig d’espai afegit a l’exterior de l’institut
Francesca Llopis EN RESiDÈNCiA a l’Institut Fort Pius: els alumnes fan balanç de la primera part del projecte
Davant la càmera de la Francesca Llopis, els estudiants parlen de l’experiència de treballar amb una artista a l’institut i comenten aquells aspectes que més els han sorprès o interessat dels icebergs.
Vegeu tots els vídeos al bloc del procés de creació de Francesca Llopis EN RESiDÈNCiA a l’Institut Fort Pius.
Mar Arza EN RESiDÈNCiA a l’Institut Narcís Monturiol: transcrivint versos amb els alfabets creats
Podeu seguir el procés de creació al bloc de Mar Arza EN RESiDÈNCiA a l’Institut Narcís Monturiol.
Robert Ferrer i Martorell EN RESiDÈNCiA a l’Institut Francisco de Goya: explorant l’abstracció fotogràficament
Podeu seguir les seves experiències al bloc de la residència de l’Institut Francisco de Goya.
Exposició “EN RESiDÈNCiA 2009-2010” al Nivell Zero de la Fundació Suñol
Del 16 de novembre a l’11 de desembre de 2010 al Nivell Zero de la Fundació Suñol (c/ Rosselló 240) es pot veure l’exposició de les tres obres realizades en la primera edició del projecte, així com els processos de creació.
- Air race, de Daniel Chust Peters EN RESiDÈNCiA a l’Institut Bernat Metge: web i bloc.
- 10.000 hores, de Salvador Juanpere EN RESiDÈNCiA a l’Institut Infanta Isabel d’Aragó: web i bloc.
- nouBARRISnou, de Lluís Sabadell Artiga EN RESiDÈNCiA a l’Institut Collserola: web i bloc.
Estudiants, professors i creadors residents de la segona edició assisteixen a la inauguració, el dilluns 15 de novembre a les 19h.
L’exposició es pot visitar de dilluns a dissabte, de 16h a 20h.
L’exposició ha estat organitzada per A Bao A Qu amb el suport de l’Institut de Cultura de l’Ajuntament de Barcelona, i la Fundació Suñol
Podeu veure el Dossier de Premsa de l’exposició “En Residència” a la Fundació Suñol.
Mar Arza EN RESiDÈNCiA a l’Institut Narcís Monturiol: creant un alfabet propi
A l’Institut Narcís Monturiol dissenyen un alfabet propi, creen segells amb aquestes lletres i les estampen creant formes diverses.
Francesca Llopis EN RESiDÈNCiA a l’Institut Fort Pius: treballant sobre la flotabilitat dels cossos
A l’Institut Fort Pius treballen sobre la flotabilitat dels cossos i fan els primers vídeos sobre aquestes experiències amb l’aigua.
Josep-Maria Balanyà EN RESiDÈNCiA a l’Institut Joan Brossa: percudint
A l’Institut Joan Brossa, després d’algunes performance de Josep-Maria Balanyà amb la seva escultura ‘Cinco exteriores k cuelgan’, són els alumnes qui percudeixen amb diverses peces metàl·liques i objectes sonors.